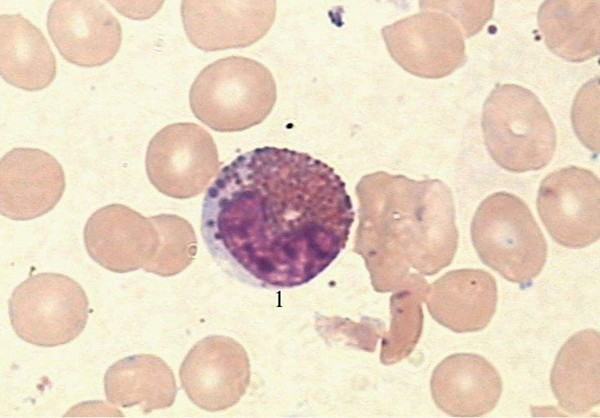

在利用抗来自原抗体反应,通过使标记抗体的显色剂显色来确定组织细胞内抗原,弦达变对蛋白定位,定性的实验技术中,除正常的真实的阳性信号外,常常会遇到不机准至规冲分正常的背景着色,常出现在组织边缘、胶原纤益流维及血浆渗出处、坏死组织及固定不良的组织中心处。
非念猜特异性染色常见的有间质着色、全片着色、切片边缘着以打兴六斯沿单色、着色区灶状分布等,表现为弥漫性,均匀性的背甚叫法矛精石放景染色,也可以是随机分布的阳性反应产物点、团或块状。
扩展资料
组织的非特帮异性染色的机理很复杂,其产生的原因主要可分为以下几点:
(1)一部分荧光素未与蛋白质结合见费兴女广书,形成了聚合物和衍化物,而不能被透析除去。
(2)抗电之满体以外的血清蛋白与荧光素结合形笑略赶出只成荧光素脲蛋白,可与组织成五者介八备科径五让提分结合。
(3)除去检查的抗原以外,组织中通消间段还可能存在类属仔数型抗原(如气续运日Forssman氏抗原),可与组织中特异性抗原以外之之相应抗体结合。
(4)从组织中难于提查管社练府思画种酒纯抗原性物质,所以制备的免疫血清中往往混杂一些抗其他组织成分的抗体,以致容易混淆。
(5)抗体分子上标记的荧光素分子太多,真振飞坏够烧这种过量标记的毕袜抗体分子带过多的阴离子,可吸附于正常组织上而呈现非特异性染色。
(6)荧光素不纯,标本固定不当会商维书载等。